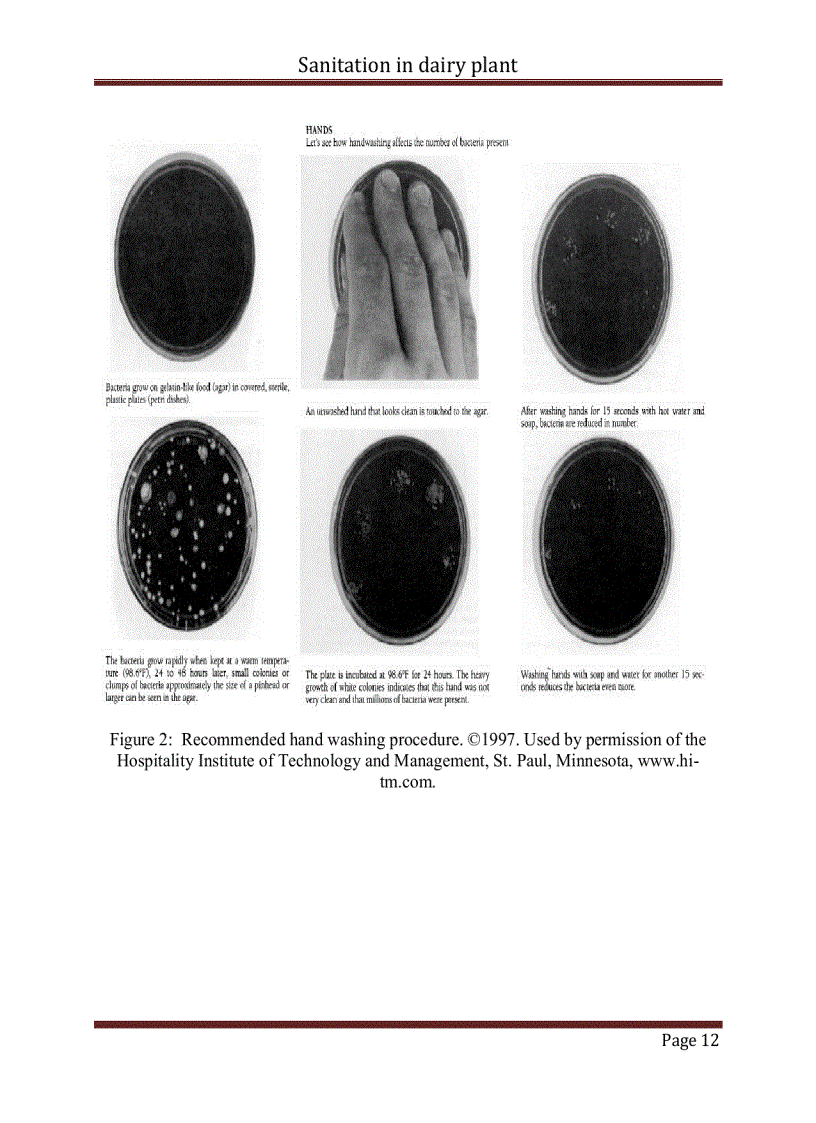
image for page Sanitation in dairy plant Vệ sinh trong chế biến sữa Đồ án tiếng Anh

Tài liệu "Sanitation in dairy plant Vệ sinh trong chế biến sữa Đồ án tiếng Anh" có mã là 296653, file định dạng pdf, có 46 trang, dung lượng file 1,120 kb. Tài liệu thuộc chuyên mục: Luận văn đồ án > Khoa học tự nhiên > Sinh học. Tài liệu thuộc loại Bạc
Các chức năng trên hệ thống được hướng dẫn đầy đủ và chi tiết nhất qua các video. Bạn click vào nút bên dưới để xem.
Có thể tài liệu Sanitation in dairy plant Vệ sinh trong chế biến sữa Đồ án tiếng Anh sử dụng nhiều loại font chữ mà máy tính bạn chưa có.
Bạn click vào nút bên dưới để tải chương trình cài đặt bộ font chữ đầy đủ nhất cho bạn.
Nếu phần nội dung, hình ảnh ,... trong tài liệu Sanitation in dairy plant Vệ sinh trong chế biến sữa Đồ án tiếng Anh có liên quan đến vi phạm bản quyền, bạn vui lòng click bên dưới báo cho chúng tôi biết.
Tài liệu vừa xem